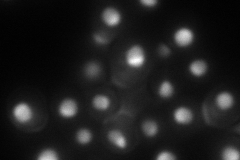
YOR078W
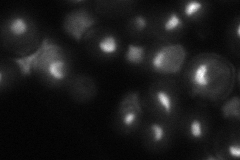
YOR078W

View description
Component of small ribosomal subunit (SSU) processosome that contains U3 snoRNA; originally isolated as bud-site selection mutant that displays a random budding pattern
Localization:
Intensity:
Fold change:
Significance:
-
C’ GFP library in SD

nucleus42.16 -
N' NOP1pr-GFP in SD

nucleolus84.6055 -
N' TEF2pr-mCherry in SD
nucleus,nucleolus85.5691 -
N' NATIVEpr-GFP in SD
nucleolus54.7757 -
N' TEF2pr-VC and Cyto-VN in SD

nucleus,nucleolus43.8633 -
C’ GFP library in SD+DTT

nucleus35.690.84No -
C’ GFP library in SD+H2O2

nucleus30.930.73No -
C’ GFP library in Starvation Media

punctateN/AN/AYes -
C’ GFP library on the background of Pup2-DaMP

nucleus -
C’ GFP library on the background of CCT mutant

nucleus39.51150.936971No
